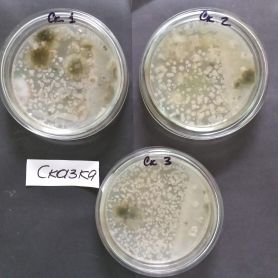

Лабораторія мікробіологічних досліджень є структурним навчальним підрозділом університету. Лабораторія створена на базі кафедри харчових технологій та готельно-ресторанної справи для організації та проведення навчальних занять з дисциплін: «Мікробіологія», «Мікробіологія, санітарія та гігієна закладів харчування» «Методи контролю харчових виробництв», та лабораторних робіт стосовно мікробіологічного контролю та забеспечення якості продукції з дисциплін «Загальні технології харчової промисловості», «Хімічні основи харчових технологій», «Технологічні властивості сировини», «Технологія м’яса, м’ясопродуктів і риби», «Технологія молока і молочних продуктів», «Технологія жирів і жирозамінників», «Технологія переробки і зберігання зерна», «Технологія цукрового виробництва», «Технологія хліба, макаронних, кондитерських виробів та харчоконцентратів», «Технологія бродильних виробництв», «Технологія полісахаридів та їх застосування у харчовій галузі» для студентів спеціальностей 241 «Готельно-ресторанна справа» та 181 «Харчові технології».
Лабораторія забезпечена необхідним оснащенням для ефективного здійснення освітнього процесу, виконання лабораторних і практичних робіт.
Матеріальна база навчальної лабораторії біохімічних досліджень включає:
1) обладнання: мікроскоп навчальний (5 шт.), мікроскоп Biolux LCD 50-2000x, мікроскоп Granum W 1002, компактна цифрова камера DCM-310, персональний комп’ютер, ламінарний бокс для роботи в асептичних умовах, аналітичні ваги OHAUS PIONEER PA214C, автоклави-стерилізатори парові ГК-100-2 (2 шт), сплітсистема, термостат ТС-80М-2, шафи сушильні ШС-3, ШЕС-3М, СНОЛ 100/350, шафа витяжна, бойлер «Thermex», вологомір AXIS ADGS 100, лампу інфрачервоного випромінювання INFRATHERM, електронні кухонні ваги MAESTRO MR1800, аквадистилятор електричний MIKROmed DE-5, електричну піч ORANIER, електроплиту HEC-150 «HILTON», фотоколориметр КФК-2-УХЛ4,2 баню водяну ЛАБ-ТБ-6/24, центрифугу ОПи-8УХЛ 4,2, рефрактометр ИРФ-454Б 830313, рН метр 150-м, термометри щупові, холодильник.
2) меблі: столи для занять та лабораторні, стільці для учнів та лабораторні, шафи для хімічного посуду, шафи для реактивів, тумби лабораторні, раковини, сушка для лабораторного посуду СУЛ – 02.
3) хімічний інвентар та реактиви: пробірки біологічні та хімічні, чашки Петрі, пікнометри та колби, мірні цилиндри, бюкси з притертими кришками, бюретки, воронки лабораторні, колби конічні, колби круглодонні, колби К’єльдаля, лопаточки та палички скляні, лупи, мензурки, піпетка піпетки градуйовані, пробірки конічні, склянки мірні, спиртівки, камери Горяєва, термометри спиртові, біологічні петлі та голки, різаки мікробіологічні, скло предметне та покривне, набори для фарбування за Грамом, барвники в асортименті, масло імерсійне (А, В), спирт медичний, ксилол.
В лабораторії мікробіологічних досліджень студенти опановують на практиці методи мікробіологічного контролю санітарно-гігієнічного стану приміщень, обладнання та продукції, зокрема: навчаються балансувати рецептури та готувати елективні поживні середовища, виділяти з продуктів, оточуючого середовища мікроорганізми у чисті культури, підтримувати їхню життєдіяльність та аналізувати їх фізіологічні і морфологічні особливості, визначати кількість КУО у повітрі, на обладнанні та у продукті, визначати відповідність мікробіологічної якості продукції нормативним вимогам; виконують наукові дослідження, отримують дані для курсових, дипломних, магістерських робіт та наукових проектів.